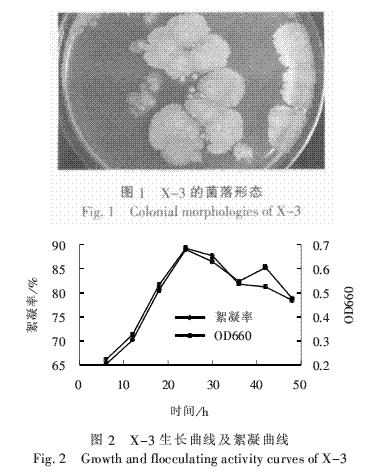

微生物絮凝剂是一类由微生物分泌的,主要成分是糖蛋白、多糖、蛋白质、纤维素、DNA等高分子物质[1-2],微生物絮凝剂本身具有生物可降解性,是一种高效、安全、无二次污染的新型絮凝剂[3-4]。
我国从20世纪80年代以来开始对生物絮凝剂的研究,并取得了相当的成就,赵继红等从活性污泥中筛选出一株活性高的微生物絮凝剂产生菌。我国生物絮凝剂的研制和应用大部分还处于实验室研究阶段,真正应用于工程实际的较少。在本研究中,拟从环境中筛选出絮凝活性高、用量少的微生物絮凝剂产生菌,并对其絮凝性能进行研究,旨在为生物絮凝剂的实际应用提供科学依据。
1.材料与方法
1.1试验材料
菌种来源:取自郑州五龙口污水处理厂曝气池的活性污泥。
分离培养基:牛肉膏蛋白胨培养基(培养细菌用)、高氏一号培养基(培养放线菌用)、查氏培养基(培养霉菌用)。
筛选培养基:葡萄糖20g,酵母浸膏0.5g,脲0.5g,K2HPO45g,KH2PO42g,NaCl0.1g,(NH4)2SO40.2g,水1000mL,pH值为7.0,115℃灭菌30min。
1.2试验方法
(1)菌种的分离与纯化。采用常规的稀释涂布法,经多次划线分离直至获得纯菌株。
(2)初筛。用250mL三角瓶装50mL培养液,灭菌后将菌株接入其中,30℃振荡培养4d,对所得培养液絮凝活性进行检测。在50mL比色试管中加入0.1g高岭土,定容至50mL,调节pH值为7.0,加少量培养液,加塞,摇匀,能使高岭土悬浊液絮凝成大颗粒即为有絮凝活性的菌株。
(3)复筛。将初筛获得的具有絮凝活性的菌株接种到装有50mL筛选培养基的灭菌后的250mL三角瓶中,30℃振荡培养72h,对所得培养液进行絮凝活性的检测,絮凝活性用絮凝率来表示。在50mL具塞比色试管中加入0.1g高岭土,定容至50mL,调节pH值为7.0,再加入2mL培养液,加塞,摇匀,静置5min,用移液管吸取上清液于比色皿中,于分光光度计在550nm处测定上清液的吸光度,以不加培养液的上清液吸光度为对照。每个样品重复3次,取其平均值。
絮凝率=(A-B)/A×100%。
(1)
式中:A———对照的吸光度;
B———加入生物絮凝剂的样品的吸光度。
(4)细菌生长曲线的测定。将筛选的絮凝活性较高的菌株用筛选培养基进行培养,每隔6h取样,以无菌培养基为参比,菌液经无菌培养基适当稀释后,用752分光光度计在660nm处测吸光度值OD660,测定该菌株的生长曲线,同时测定絮凝率。
(5)培养条件试验。对筛选出来的菌株,采用正交试验,选用L9(34)正交表,考察的因子及其水平见表1。

(6)絮凝剂的提取及其性能分析。将菌株X-3的培养液在10000r/min条件下离心15min,去除菌体。在上清液中加入体积比为2∶1左右的4℃无水冰乙醇,振荡至出现白色丝状絮体,离心去上清液,将沉淀物重新溶于水。重复上述操作2次,将析出的物质离心收集、冷冻干燥即得絮凝剂粗品。取絮凝剂粗品0.002g溶于2mL蒸馏水中,采用Molish反应检测絮凝剂中是否含糖,用茚三酮显色反应检测絮凝剂中是否含有蛋白质。
2.结果和讨论
2.1菌株分离纯化与初筛
将采集的样品在培养基上培养,共取得30株纯菌株,并进行编号,见表2。

从结果来看,污泥中微生物包括细菌、放线菌和霉菌,放线菌数量较多。
将所得的纯菌株进行初筛,获得了6株具有较好絮凝性的絮凝剂产生菌,其中细菌3株,放线菌3株。
2.2复筛结果
将初筛具有较好絮凝性的菌株进行复筛,其中絮凝活性最高的一株细菌絮凝率为90.5%,菌株沉降性能好,菌悬液浓度较低,表明该菌株产微生物絮凝剂能力强,且培养液絮凝活性好。因此,以该菌株作为后续研究对象,命名为X-3。
2.3菌株鉴定
从菌株的培养特征、形态特征、生理生化反应等特征进行鉴定,该菌株在牛肉膏蛋白胨平板上菌落呈圆形,边缘不规则,个体较大(见图1),芽孢中生、不膨大,V-P反应阴性,接触酶阳性。从葡萄糖、木糖、阿拉伯糖、甘露醇产酸不产气。革兰氏染色为阳性,为芽孢杆菌属。该菌在筛选培养基下培养的生长曲线和絮凝曲线见图2。由图2可知,该菌生长数量与絮凝率基本上是正相关。该菌生长速率较快,12h后即进入对数生长期,24h进入高峰期,此后缓慢下降,生长速率比此前报道筛选的絮凝剂产生菌快[10-11]。而絮凝率与生长情况类似,因此收获微生物絮凝剂最好的时期是对数生长后期或稳定期。
2.4正交试验
由于絮凝性能和生长状况都是筛选及培养的重要指标,因此,在本试验中,以表征絮凝性能的絮凝率和表征细菌生长的OD值的乘积作为综合评分来评价培养条件。正交试验结果与分析见表3。

从表3可以看出,各因素最高平均综合分的条件分别为pH值为7,葡萄糖质量浓度为10g/L,酵母膏质量浓度为15g/L,温度为20℃,即A2B2C3D1,说明在pH值中性条件下,絮凝率和微生物生长最佳,一定范围内,随着葡萄糖和酵母膏浓度及温度增加,可以提高絮凝率和细菌数量。由极差分析可知,对絮凝率的影响的大小次序为:温度>葡萄糖浓度>酵母膏浓度>pH值。因而培养微生物产生菌时,一定范围内,环境温度对絮凝剂产生和细菌生长影响最大,是最主要的影响因素,葡萄糖投加量次之,pH值影响最小,说明该菌对pH值的适应性较强。由于关键因素对指标影响大,因此必须控制在最佳水平上。考虑到投加的葡萄糖和酵母膏没有被细菌完全利用,在培养基中有部分残留,而且葡萄糖、酵母膏质量浓度为10g/L时,其综合评分降幅不大,在生产上,控制葡萄糖、酵母膏质量浓度为10g/L比较适宜,因此培养X-3菌生产絮凝剂的最佳条件为:温度20℃,葡萄糖质量浓度10g/L,酵母膏质量浓度10g/L,pH值为7。
2.5絮凝剂有效成分的分析
将菌株X-3培养液用1.2节方法
(6)提取微生物絮凝剂,100mL培养液中可提取絮凝剂粗品0.064g(干重)。提取的生物絮凝剂在Molish反应中无明显的糖色反应,而在茚三酮反应中则显示出深紫色,表明该絮凝剂的主要成分是蛋白质。为了进一步了解絮凝剂的结构及性能,将所得絮凝剂提纯并用傅立业红外光谱仪,对样品压片后进行红外光谱测试,见图3。

由图3可以知道,微生物絮凝剂的红外光谱图显示其具有蛋白质特征,在3200~3500cm-1内有强且宽的吸收峰,波峰在3296.8cm-1处,为N—H键伸缩振动,在1020~1220cm-1有一吸收峰,最大吸收波长在1116.1cm-1处,为C—N键伸缩振动,说明絮凝剂中含有—NH2;在2500~3000cm-1处有一中强吸收峰,最大吸收波长在2927.2cm-1处,为O—H键伸缩振动,1653.9cm-1处的吸收峰是C==O伸缩振动形成的,1240.9cm-1处的吸收峰是C—O键伸缩振动形成的,说明絮凝剂中含有—COOH;又因3296.8cm-1处的吸收峰是N—H键伸缩振动形成的,1653.9cm-1处的吸收峰是C==O伸缩振动形成的,说明絮凝剂中含有—CONH。
2.6废水处理试验
为了验证生物絮凝剂对废水的处理效果,在每100mL废水中加入2mL离心X-3菌上清液,以加2mL无菌水的废水为对照,计算絮凝率,结果见表4。由表4可知,X-3产生的生物絮凝剂对印染、皮革、造纸废水、生活污水等均有较好的絮凝沉淀去除效果,特别是皮革废水,絮凝率高达91.6%。

3.结论
(1)从城市污水处理厂活性污泥中分离出1株能产生高效絮凝活性絮凝剂的菌株,命名为X-3,经初步鉴定为芽孢杆菌属。该菌生长较快,12h就进入对数期,絮凝曲线与生长曲线呈正相关。
(2)对X-3所产絮凝剂进行提取,经初步测定絮凝剂主要成分为蛋白质。在一定范围内,环境温度是影响X-3絮凝性能的最主要因素,投加适量葡萄糖可以提高絮凝剂产量,pH值变化对絮凝性能影响不明显。培养X-3菌生产絮凝剂的最佳条件为:温度20℃,葡萄糖质量浓度10g/L,酵母膏质量浓度10g/L,pH值为7。
(3)生物絮凝剂对实际废水絮凝试验表明,X-3所产絮凝剂对印染、皮革、造纸废水、生活污水等均有较好的絮凝沉淀去除效果,具有良好的应用前景。














